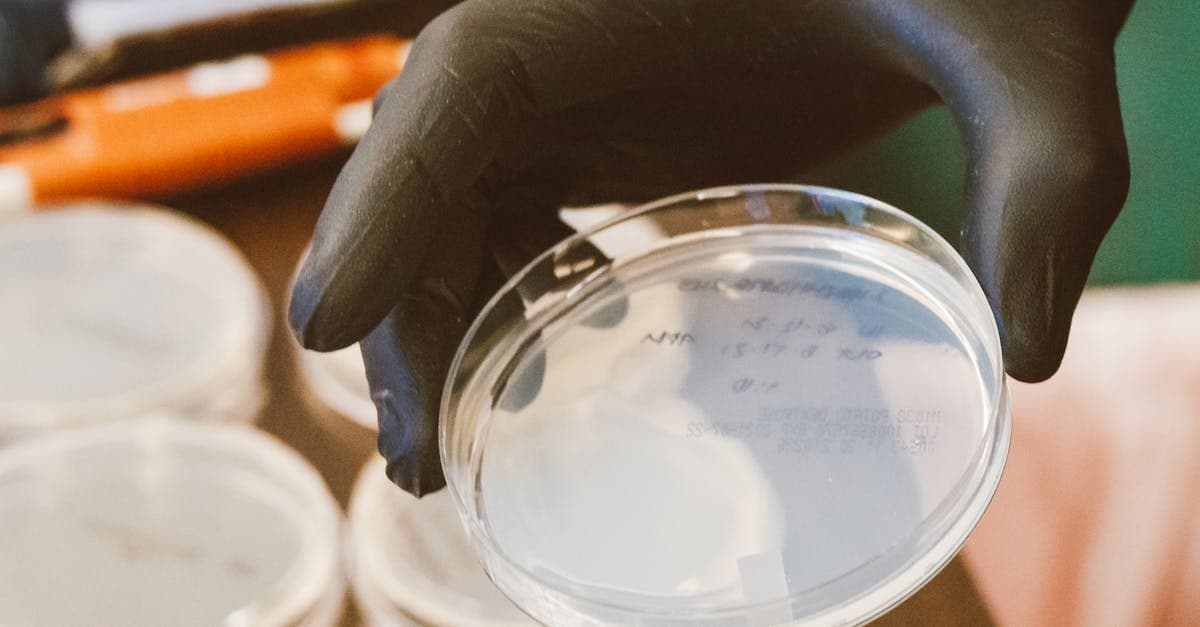
میکروب‌شناسی

چطور نتایج آزمایشم را بخوانم؟
راهنمای ساده و قابل فهم برای درک نتایج آزمایشات آزمایشگاهی شما. با زبان ساده، بدون پیچیدگیهای پزشکی.
💡 نکته مهم
این راهنما فقط برای کمک به درک اولیه نتایج شماست. حتماً نتایج را با دکتر خود بررسی کنید.
انتخاب نوع آزمایش

راهنمای آزمایشات خون
راهنمای تفسیر نتایج آزمایشات خون شامل CBC، بیوشیمی و هورمونها
نکات مهم
محدودههای طبیعی
مراجعه فوری به پزشک
اشتباهات رایج
مشاوره با پزشک متخصص
این راهنما صرفاً جهت آگاهی کلی ارائه شده است. برای تفسیر دقیق نتایج آزمایش، تشخیص و درمان، حتماً با پزشک متخصص مشورت کنید و از خودتشخیصی پرهیز نمایید.

راهنمای آزمایشات ادرار
تفسیر نتایج آنالیز ادرار و مایعات بدن
نکات مهم
محدودههای طبیعی
مراجعه فوری به پزشک
اشتباهات رایج
مشاوره با پزشک متخصص
این راهنما صرفاً جهت آگاهی کلی ارائه شده است. برای تفسیر دقیق نتایج آزمایش، تشخیص و درمان، حتماً با پزشک متخصص مشورت کنید و از خودتشخیصی پرهیز نمایید.

راهنمای میکروبشناسی
راهنمای درک نتایج کشت و آنتیبیوگرام
نکات مهم
محدودههای طبیعی
مراجعه فوری به پزشک
اشتباهات رایج
مشاوره با پزشک متخصص
این راهنما صرفاً جهت آگاهی کلی ارائه شده است. برای تفسیر دقیق نتایج آزمایش، تشخیص و درمان، حتماً با پزشک متخصص مشورت کنید و از خودتشخیصی پرهیز نمایید.

راهنمای پاتولوژی
تفسیر گزارشات بافتشناسی و سیتولوژی
نکات مهم
محدودههای طبیعی
مراجعه فوری به پزشک
اشتباهات رایج
مشاوره با پزشک متخصص
این راهنما صرفاً جهت آگاهی کلی ارائه شده است. برای تفسیر دقیق نتایج آزمایش، تشخیص و درمان، حتماً با پزشک متخصص مشورت کنید و از خودتشخیصی پرهیز نمایید.

راهنمای ژنتیک
راهنمای درک آزمایشات ژنتیکی و غربالگری
نکات مهم
محدودههای طبیعی
مراجعه فوری به پزشک
اشتباهات رایج
مشاوره با پزشک متخصص
این راهنما صرفاً جهت آگاهی کلی ارائه شده است. برای تفسیر دقیق نتایج آزمایش، تشخیص و درمان، حتماً با پزشک متخصص مشورت کنید و از خودتشخیصی پرهیز نمایید.
راهنمای سرولوژی
تفسیر نتایج آزمایشات ایمونولوژی و سرولوژی
نکات مهم
محدودههای طبیعی
مراجعه فوری به پزشک
اشتباهات رایج
مشاوره با پزشک متخصص
این راهنما صرفاً جهت آگاهی کلی ارائه شده است. برای تفسیر دقیق نتایج آزمایش، تشخیص و درمان، حتماً با پزشک متخصص مشورت کنید و از خودتشخیصی پرهیز نمایید.
نکات مهم در تفسیر نتایج
برای درک بهتر نتایج آزمایشات، نکات زیر را در نظر داشته باشید
مقادیر مرجع
همیشه نتایج خود را با مقادیر مرجع مندرج در گزارش مقایسه کنید
شرایط نمونهگیری
شرایط نمونهگیری مانند ناشتایی میتواند بر نتایج تأثیر بگذارد
تکرار آزمایش
در صورت نتایج غیرطبیعی، ممکن است نیاز به تکرار آزمایش باشد
مشاوره پزشک
برای تفسیر دقیق حتماً با پزشک معالج خود مشورت کنید
تاریخچه پزشکی
سابقه بیماری و داروهای مصرفی بر نتایج تأثیرگذار است
پیگیری منظم
برخی آزمایشات نیاز به پیگیری و کنترل منظم دارند
سوال یا نگرانی دارید؟
تیم متخصص ما آماده پاسخگویی به سوالات شما در خصوص نتایج آزمایشات میباشد